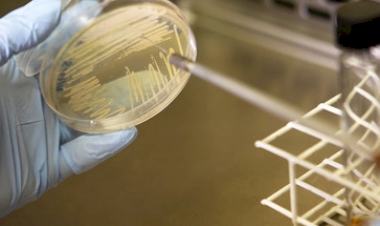
Seminário da Embrapa discute insumos biológicos na agricultura

Fenasoja 2024: Caminhos da Soja revelam curiosidades e fatos marcantes da história da agricultura na região de Santa Rosa

Os Caminhos da Soja, atração permanente da Fenasoja 2024, que acontece em Santa Rosa, foi aberto oficialmente em ato realizado neste sábado (30/11). Na Fenasoja, em que são celebrados os 100 anos da Soja no Brasil, o público tem a oportunidade de reviver momentos marcantes e ativar memórias afetivas no espaço que remonta à evolução da agricultura e das comunidades rurais da região de Santa Rosa.
O atrativo preparado pela Emater/RS-Ascar em parceria com a Comissão de Agricultura, Soja e Derivados da Fenasoja 2024 deve receber milhares de visitantes durante a feira. Estão confirmadas excursões de agricultores vindas de mais de 40 municípios da região, além de aproximadamente 3 mil estudantes das escolas da rede pública municipal de Santa Rosa. Além disso, é atração permanente, que os visitantes podem conferir até o dia 08/12.
Prestigiaram o ato de abertura, o presidente e o vice-presidente da Fenasoja 2024, Dário Germano e Marcos Eduardo Servar, o presidente da Emater/RS, Luciano Schwerz, o diretor técnico da Emater/RS, Claudinei Baldissera, a presidente da Comissão de Agricultura, Soja e Derivados da Fenasoja 2024, Vanessa Gnoatto, gerente regional e gerente adjunta da Emater/RS-Ascar, Valmir Thume e Ivânia Polaczinski, entre outras lideranças.
Vindo dos Estados Unidos, onde a família vive e possui uma fazenda com soja, o Pastor Valter Lehenbauer, neto do Pastor Lehenbauer, que trouxe os primeiros grãos de soja à Santa Rosa há 100 anos, prestigiou os Caminhos da Soja. Elev falou sobre as cartas recebidas do avô, enquanto vivia no Brasil, relatando a preocupação em apresentar uma alternativa de alimento para a comunidade onde vivia, fato que o levou a trazer os primeiros grãos de soja, visando a alimentação humana. “Se meu avô estivesse aqui, com certeza choraria de emoção ao ver a proporção que o gesto singelo feito há 100 anos tomou, quando um punhado de sementes foi trazido dos Estados Unidos para Santa Rosa a fim de apresentar a alternativa às famílias que tinham necessidade”, declarou Valter.
MINI MUNDO DA AGRICULTURA FAMILIAR
Quem passa pelo espaço, localizado em frente à Cozinha Experimental da Soja, se encanta com uma maquete de 75m², onde são recontados períodos marcantes da evolução da agricultura na região de Santa Rosa, desde o sistema adotado pelos guaranis e reduções jesuítas até a contemporaneidade.
Para a construção da maquete, além de réplicas de propriedades e comunidades rurais, foram utilizadas mais de 800 mudas de árvores nativas cedidas pela Cooperativa de Energia Cooperluz e outras 300 pelo Viveiro Municipal de Santa Rosa.
Assessoria de Imprensa da Emater/RS-Ascar - Regional de Santa Rosa

Comentários (0)